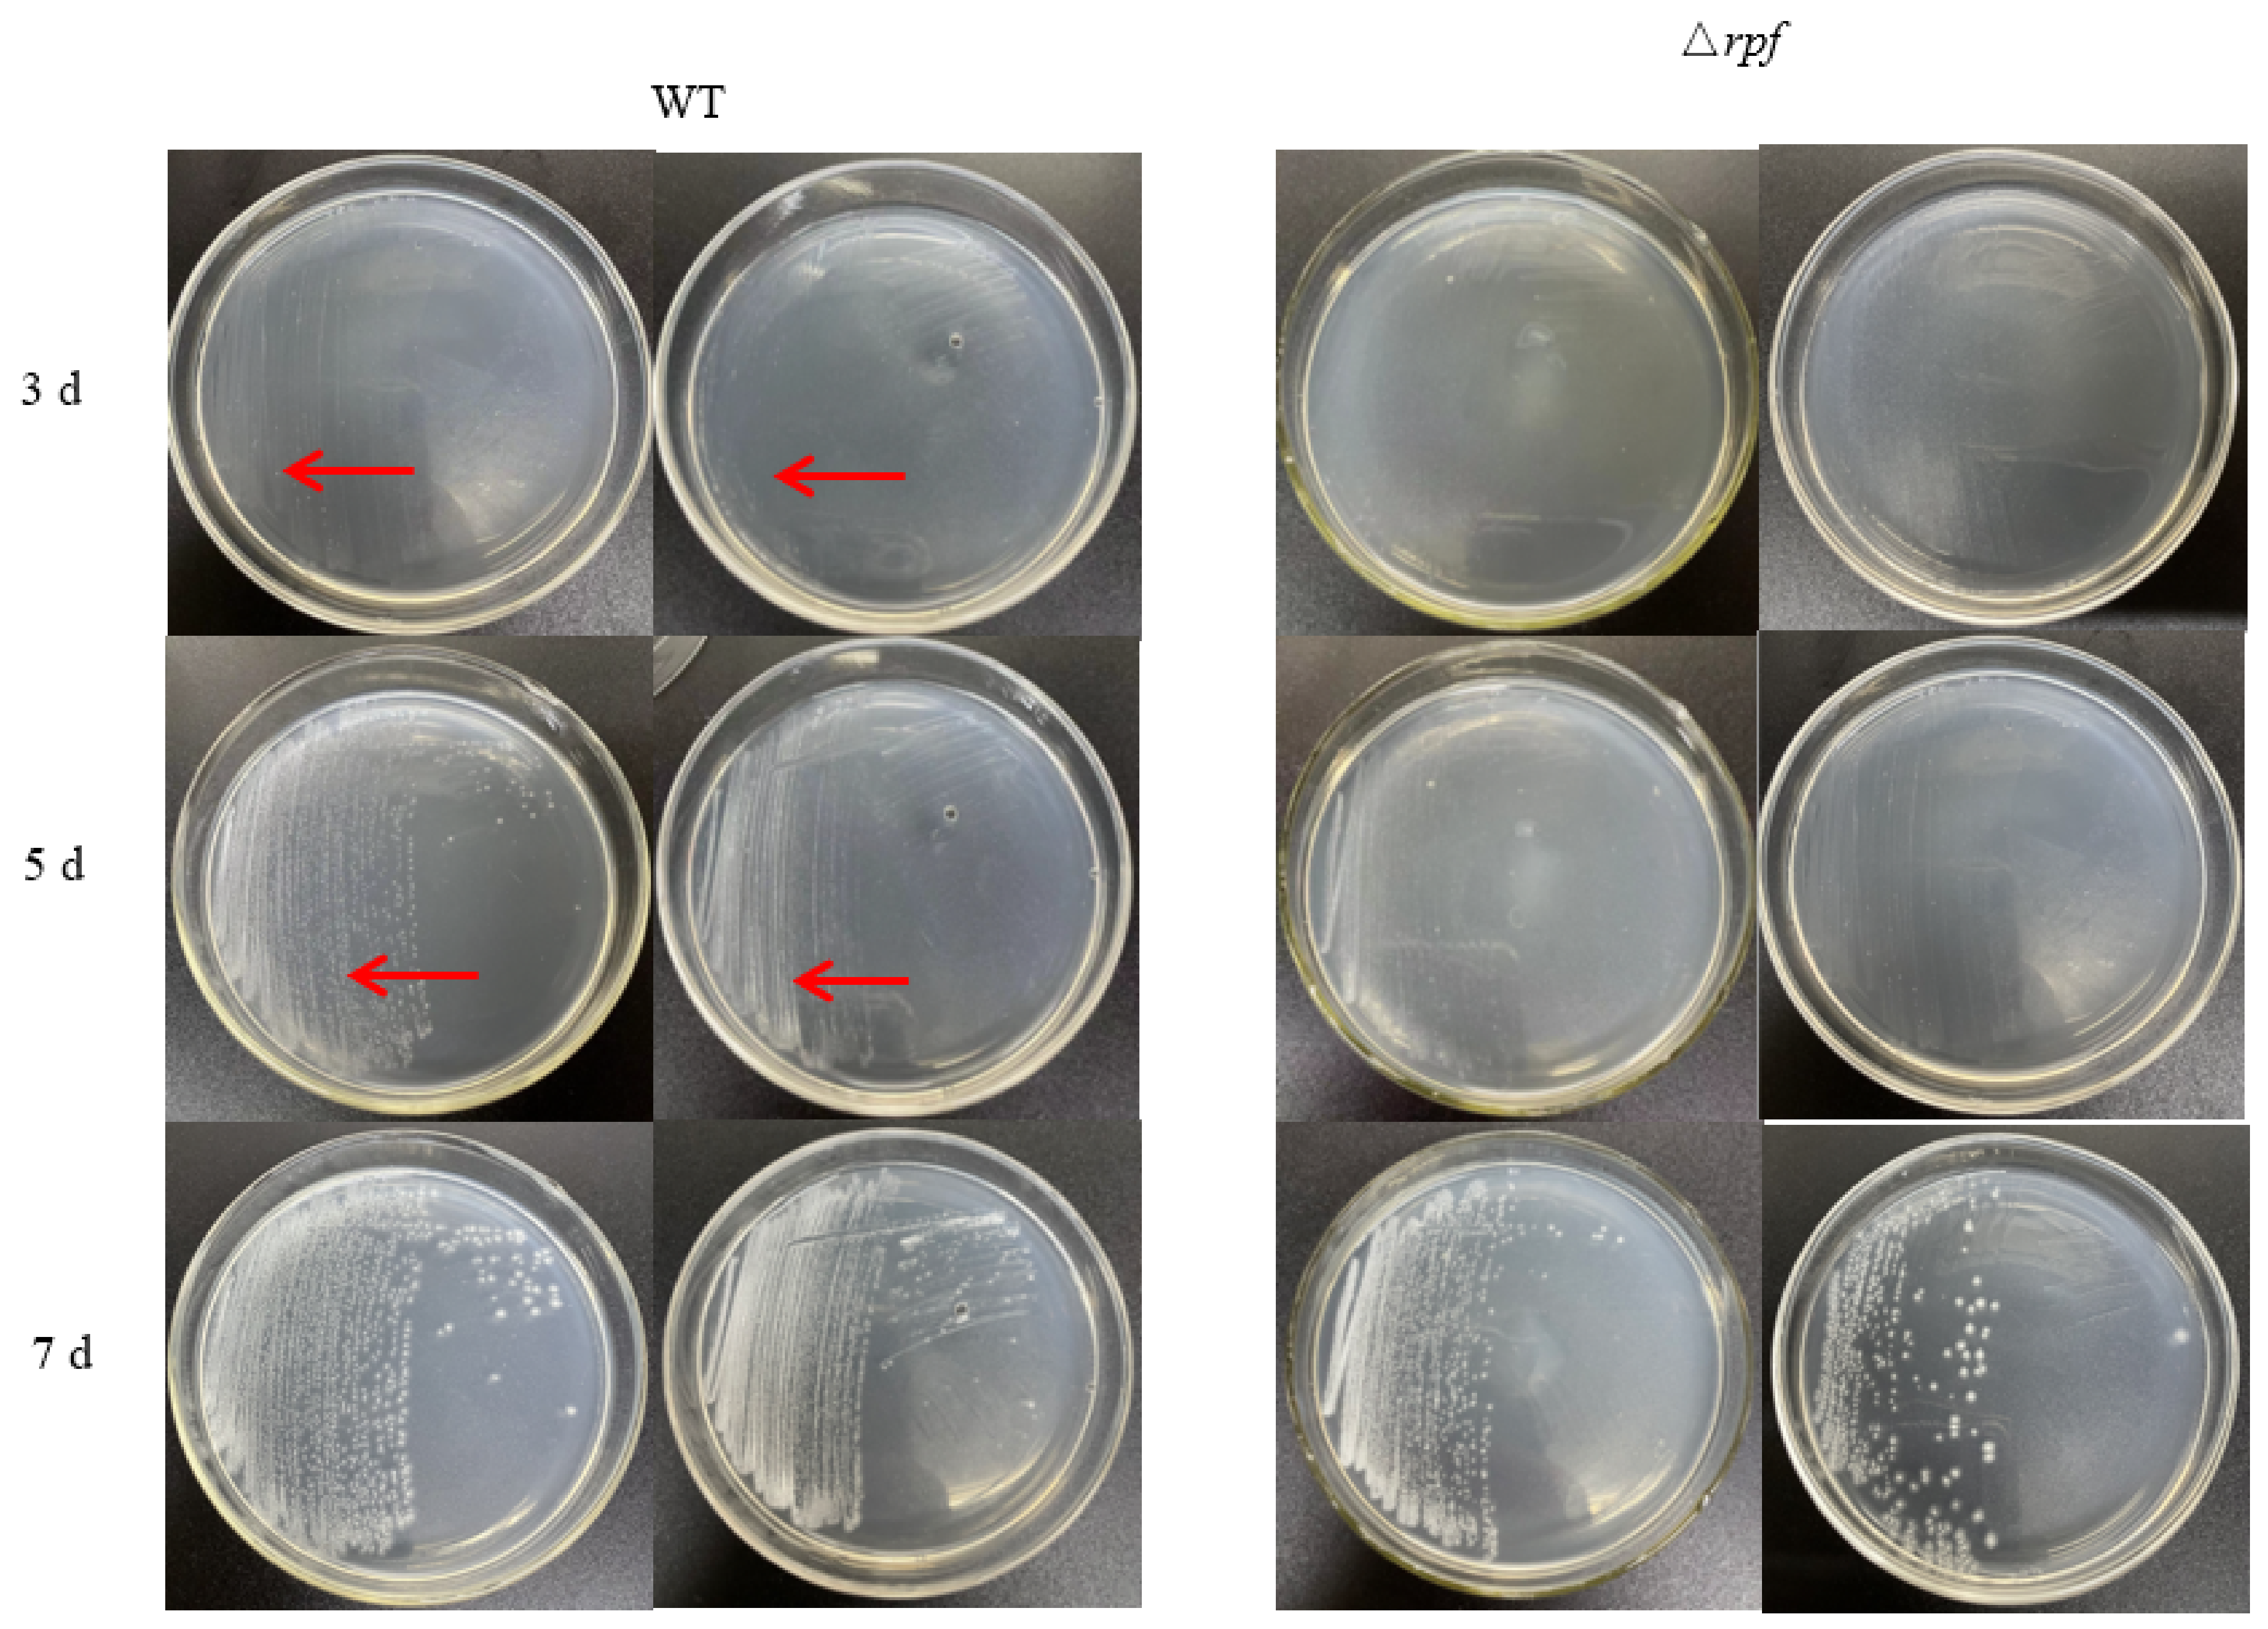
Microorganisms 11 00485 g007 Microorganisms 11 00485 g007

Role of Resuscitation Promoting Factor-like Protein from Nocardiopsis halophila
Abstract
1. Introduction
2. Materials and Methods
2.1. Bioinformatics Analysis of Rpf Gene of N. halophila CGMCC 4.1195T
2.2. Strains and Plasmids
2.3. Strain Culture
2.4. Gene Cloning and Construction of Expression Vector
2.5. Expression and Purification of Rpf Protein
2.6. Induction of VBNC State
2.7. Validation of Rpf Protein on the Resuscitation of VBNC N. halophila
2.8. Construction of Rpf Gene Knockout Vector
2.9. Deletion of N. halophila CGMCC 4.1195T Rpf Gene
2.10. Comparison of the Growth of Wild Type Strain and Δrpf Strain
2.11. Statistical Analysis
3. Results
3.1. Function Domains of Rpf Protein Encoded by Rpf Gene of N. halophila CGMCC 4.1195T
3.2. Homology of Rpf Proteins between N. halophila CGMCC 4.1195T and of Other Species
3.3. Tertiary Structure Prediction of Rpf Protein
3.4. Purification and Characterization of Rpf Protein from N. halophila CGMCC 4.1195T
3.5. Validation of Rpf Protein on the Resuscitation of VBNC Bacteria
3.6. Effects of Rpf Gene Deletion on Growth and Sporulation of Strain
4. Discussion
Author Contributions
Funding
Data Availability Statement
Acknowledgments
Conflicts of Interest
References
- Mukamolova, G.V.; Kaprelyants, A.S.; Young, D.I.; Young, M.; Kell, D.B. A bacterial cytokine. Proc. Natl. Acad. Sci. USA 1998, 95, 8916–8921. [Google Scholar] [CrossRef] [PubMed]
- Mukamolova, G.V.; Kormer, S.; Kell, D.B.; Kaprelyants, A.S. Stimulation of the multiplication of Micrococcus luteus by an autocrine growth factor. Arch. Microbiol. 1999, 172, 9–14. [Google Scholar] [CrossRef] [PubMed]
- Nikitushkin, V.D.; Demina, G.R.; Kaprelyants, A.S. Rpf Proteins Are the Factors of Reactivation of the Dormant Forms of Actinobacteria. Biochemistry 2016, 81, 1719–1734. [Google Scholar] [CrossRef] [PubMed]
- Ravagnani, A.; Finan, C.; Young, M. A novel firmicute protein family related to the actinobacterial resuscitation-promoting factors by non-orthologous domain displacement. BMC Genom. 2005, 6, 39. [Google Scholar] [CrossRef] [PubMed]
- Biasini, M.; Bienert, S.; Waterhouse, A.; Arnold, K.; Studer, G.; Schmidt, T.; Kiefer, F.; Gallo Cassarino, T.; Bertoni, M.; Bordoli, L.; et al. SWISS-MODEL: Modelling protein tertiary and quaternary structure using evolutionary information. Nucleic Acids Res. 2014, 42, W252–W258. [Google Scholar] [CrossRef]
- Sexton, D.L.; St-Onge, R.J.; Haiser, H.J.; Yousef, M.R.; Brady, L.; Gao, C.; Leonard, J.; Elliot, M.A. Resuscitation-promoting factors are cell wall-lytic enzymes with important roles in the germination and growth of Streptomyces coelicolor. J. Bacteriol. 2015, 197, 848–860. [Google Scholar] [CrossRef]
- Hartmann, M.B.A.; Niehaus, K.; Pühler, A.; Tauch, A.; Kalinowski, J. The glycosylated cell surface protein Rpf2, containing a resuscitation-promoting factor motif, is involved in intercellular communication of Corynebacterium glutamicum. Arch. Microbiol. 2004, 182, 299–312. [Google Scholar] [CrossRef]
- Downing, K.J.; Mischenko, V.V.; Shleeva, M.O.; Young, D.I.; Young, M.; Kaprelyants, A.S.; Apt, A.S.; Mizrahi, V. Mutants of Mycobacterium tuberculosis lacking three of the five rpf-like genes are defective for growth in vivo and for resuscitation in vitro. Infect. Immun. 2005, 73, 3038–3043. [Google Scholar] [CrossRef]
- Kana, B.D.; Gordhan, B.; Downing, K.J.; Sung, N.; Vostroktunova, G.; Machowski, E.E.; Tsenova, L.; Young, M.; Kaprelyants, A.; Kaplan, G.; et al. The resuscitation-promoting factors of Mycobacterium tuberculosis are required for virulence and resuscitation from dormancy but are collectively dispensable for growth in vitro. Mol. Microbiol. 2008, 67, 672–684. [Google Scholar] [CrossRef]
- Russell-Goldman, E.; Xu, J.; Wang, X.; Chan, J.; Tufariello, J.M. A Mycobacterium tuberculosis Rpf. double-knockout strain exhibits profound defects in reactivation from chronic tuberculosis and innate immunity phenotypes. Infect. Immun. 2008, 76, 4269–4281. [Google Scholar] [CrossRef]
- Uhía, I.; Krishnan, N.; Robertson, B.D. Characterising resuscitation promoting factor fluorescent-fusions in mycobacteria. BMC Microbiol. 2018, 18, 30. [Google Scholar] [CrossRef]
- Rosser, A.; Stover, C.; Pareek, M.; Mukamolova, G.V. Resuscitation-promoting factors are important. determinants of the pathophysiology in Mycobacterium tuberculosis infection. Crit. Rev. Microbiol. 2017, 43, 621–630. [Google Scholar] [CrossRef]
- Pourazar, D.S.; Taala, A.; Masoumi, M.; Ebrahimzadeh, N.; Fateh, A.; Siadat, S.D.; Vaziri, F. Sub-minimum inhibitory concentration of rifampin: A potential risk factor for resuscitation of Mycobacterium tuberculosis. Antimicrob. Resist. Infect. Control 2017, 6, 116. [Google Scholar] [CrossRef]
- Gao, H.; Bai, Y.; Xue, Y.; Wang, L.; Fan, A.; Ding, X.; Xu, Z. Expression, purification, and. characterization of soluble RpfD with high bioactivity as a recombinant protein in Mycobacterium vaccae. Protein Expr. Purif. 2007, 55, 112–118. [Google Scholar] [CrossRef]
- Seidi, K.; Jahanban-Esfahlan, R. A novel approach to eradicate latent TB: Based on resuscitation. promoting factors. J. Med. Hypotheses Ideas 2013, 7, 69–74. [Google Scholar] [CrossRef]
- Huang, W.; Qi, Y.J.; Diao, Y.J.; Yang, F.; Zha, X.D.; Ren, C.P.; Huang, D.K.; Franken, K.L.; Ottenhoff, T.H.; Wu, Q.S.; et al. Use of resuscitation-promoting factor proteins improves the sensitivity of culture-based tuberculosis testing in special samples. Am. J. Respir. Crit. Care Med. 2014, 189, 612–614. [Google Scholar] [CrossRef]
- Arroyo, L.; Marín, D.; Franken, K.L.M.C.; Ottenhoff, T.H.M.; Barrera, L.F. Potential of DosR and Rpf. antigens from Mycobacterium tuberculosis to discriminate between latent and active tuberculosis in a tuberculosis endemic population of Medellin Colombia. BMC Infect. Dis. 2018, 18, 26. [Google Scholar] [CrossRef]
- Ye, Z.; Li, H.; Jia, Y.Y.; Fan, J.H.; Wan, J.X.; Guo, L.; Su, X.; Zhang, Y.; Wu, W.M.; Shen, C. Supplementing resuscitation-promoting factor (Rpf) enhanced biodegradation of polychlorinated biphenyls (PCBs) by Rhodococcus biphenylivorans strain TG9T. Environ. Pollut. 2020, 263, 114488. [Google Scholar] [CrossRef]
- Liu, Y.D.; Su, X.M.; Lu, L.; Ding, L.X.; Shen, C.F. A novel approach to enhance biological nutrient. removal using a culture supernatant from Micrococcus luteus containing resuscitation-promoting factor (Rpf) in SBR process. Environ. Sci. Pollut. Res. Int. 2016, 23, 4498–4508. [Google Scholar] [CrossRef]
- Murugan, K.; Vasudevan, N. Intracellular toxicity exerted by PCBs and role of VBNC bacterial strains in biodegradation. Ecotoxicol. Environ. Saf. 2018, 157, 40–60. [Google Scholar] [CrossRef]
- Su, X.M.; Li, S.; Xie, M.Q.; Tao, L.Q.; Zhou, Y.; Xiao, Y.Y.; Lin, H.J.; Chen, J.R.; Sun, F.Q. Enhancement of polychlorinatedbiphenyl biodegradation by resuscitation promoting factor (Rpf) and Rpf-responsive bacterial community. Chemosphere 2021, 26, 128283. [Google Scholar] [CrossRef] [PubMed]
- Su, X.M.; Wang, Y.; Xue, B.B.; Zhang, Y.G.; Mei, R.W.; Zhang, Y.; Hashmi, M.Z.; Lin, H.; Chen, J.; Sun, F. Resuscitation of functional bacterial community for enhancing biodegradation of phenol under high salinity conditions based on Rpf. Bioresour. Technol. 2018, 261, 394–402. [Google Scholar] [CrossRef] [PubMed]
- Yu, C.N.; Liu, Y.; Jia, Y.Y.; Su, X.M.; Lu, L.; Ding, L.X.; Shen, C. Extracellular organic matter from Micrococcus luteus containing resuscitation-promoting factor in sequencing batch reactor for effective nutrient and phenol removal. Sci. Total Environ. 2020, 727, 138627. [Google Scholar] [CrossRef] [PubMed]
- Jin, Y.; Gan, G.; Yu, X.Y.; Wu, D.D.; Zhang, L.; Yang, N.; Hu, J.D.; Liu, Z.H.; Zhang, L.X.; Hong, H.C. Isolation of viable but non-culturable bacteria from printing and dyeing wastewater bioreactor based on resuscitation promoting factor. Curr. Microbiol. 2017, 74, 787–797. [Google Scholar] [CrossRef]
- Su, X.M.; Shen, H.; Yao, X.; Ding, L.X.; Yu, C.; Shen, C.F. A novel approach to stimulate the. biphenyl-degrading potential of bacterial community from PCBs-contaminated soil of e-waste recycling sites. Bioresour. Technol. 2013, 146, 27–34. [Google Scholar] [CrossRef]
- Han, Z.; Lin, Q.H.; Zhang, S.S.; Zhou, X.R.; Li, S.; Sun, F.Q.; Shen, C.F.; Su, X.M. High PCBs mineralization capability of a resuscitated strain Bacillus sp. LS1 and its survival in PCB-contaminated soil. Sci. Total Environ. 2023, 856, 159224. [Google Scholar] [CrossRef]
- Su, X.M.; Xie, M.Q.; Han, Z.; Xiao, Y.Y.; Wang, R.; Shen, C.F.; Hashmi, M.Z.; Sun, F.Q. Resuscitation-promoting factor accelerates enrichment of highly active tetrachloroethene/polychlorinated biphenyl-dechlorinating cultures. Appl. Environ. Microbiol. 2023, 89, e0195122. [Google Scholar] [CrossRef]
- Wang, Y.; Shi, J.; Tang, L.; Zhang, Y.; Zhang, Y.; Zhang, X. Evaluation of Rpf protein of Micrococcus. luteus for cultivation of soil actinobacteria. Syst. Appl. Microbiol. 2021, 44, 126234. [Google Scholar] [CrossRef]
- Takahashi, Y.; Omura, S. Isolation of new actinomycete strains for the screening of new bioactive compounds. J. Gen. Appl. Microbiol. 2003, 49, 141–154. [Google Scholar] [CrossRef]
- Watve, M.G.; Tickoo, R.; Jog, M.M.; Bhole, B.D. How many antibiotics are produced by the genus. Streptomyces? Arch. Microbiol. 2001, 176, 386–390. [Google Scholar] [CrossRef]
- Messis, A.; Azzeddine, B.; Mouloud, K.; Said, B. Taxonomy and Study of Antimicrobial Activity of Two Halophilic Actinomycetes AH1 and AH2 Isolated from a Saline Soil of Bejaia (Algeria). Res. Rev. BioSci. 2012, 6, 328–334. [Google Scholar]
- Tian, S.Z.; Pu, X.; Luo, G.; Zhao, L.X.; Xu, L.H.; Li, W.J.; Luo, Y. Isolation and characterization of. new p-Terphenyls with antifungal, antibacterial, and antioxidant activities from halophilic actinomycete Nocardiopsis gilva YIM 90087. J. Agric. Food. Chem. 2013, 61, 3006–3012. [Google Scholar] [CrossRef]
- Kim, S.H.; Shin, Y.; Lee, S.H.; OH, K.B.; Lee, S.K.; Shin, J.; Oh, D.C. Salternamides A-D from a. Halophilic Streptomyces sp. Actinobacterium. J. Nat. Prod. 2015, 78, 836–843. [Google Scholar] [CrossRef]
- Zhang, L.; Zhang, J.; Ren, B.; Lu, W.; Hou, C.; Wang, J.; Ma, X.; Ma, R.; Liu, M.; Liu, Z.; et al. Characterization of anti-BCG benz[α]anthraquinones and new siderophores from a Xinjiang desert-isolated rare actinomycete Nocardia sp. XJ31. Appl. Microbiol. Biotechnol. 2020, 104, 8267–8278. [Google Scholar] [CrossRef]
- Choi, B.K.; Park, S.Y.; Choi, D.K.; Shin, B.; Shin, Y.H.; OH, D.C.; Lee, H.S.; Lee, H.S.; Lee, Y.J.; Lee, J.S.; et al. Streptoglycerides A-D with a Rare 6/5/5 Tricyclic Ring Skeleton from a Marine Actinomycete Streptomyces species. Org. Lett. 2018, 20, 6037–6040. [Google Scholar] [CrossRef]
- Sexton, D.L.; Herlihey, F.A.; Brott, A.S.; Crisante, D.A.; Shepherdson, E.; Clarke, A.J.; Elliot, M.A. Roles of LysM and LytM domains in resuscitation-promoting factor (Rpf) activity and Rpf-mediated peptidoglycan cleavage and dormant spore reactivation. J. Biol. Chem. 2020, 295, 9171–9182. [Google Scholar] [CrossRef]
- Cohen-gonsaud, M.B.P.; Bagnéris, C.; Henderson, B.; Ward, J.; Roumestand, C.; Keep, N.H. The. structure of a resuscitation-promoting factor domain from Mycobacterium tuberculosis shows homology to lysozymes. Nat. Struct. Mol. Biol. 2005, 12, 270–273. [Google Scholar] [CrossRef]
- Mukamolova, G.V.; Murzin, A.; Salina, E.G.; Demina, G.R.; Kell, D.B.; Kaprelyants, A.S.; Young, M. Muralytic activity of Micrococcus luteus Rpf and its relationship to physiological activity in promoting bacterial growth and resuscitation. Mol. Microbiol. 2006, 59, 84–98. [Google Scholar] [CrossRef]
- Hett, E.C.; Deng, L.L.; Rubin, E.J. A mycobacterial enzyme essential for cell division synergizes with. resuscitation-promoting factor. PLoS. Pathog. 2008, 4, e1000001. [Google Scholar] [CrossRef]
- Ruggiero, A.; Tizzano, B.; Pedone, E.; Pedone, C.; Wilmanns, M.; Berisio, R. Crystal structure of the resuscitation-promoting factor (△DUF) RpfB from M. tuberculosis. J. Mol. Biol. 2009, 385, 153–162. [Google Scholar] [CrossRef]
- Cohen-Gonsaud, M.K.N.; Davies, A.P.; Ward, J.; Henderson, B.; Labesse, G. Resuscitation-promoting. factors possess a lysozyme-like domain. Trends Biochem. Sci. 2004, 29, 7–10. [Google Scholar] [CrossRef] [PubMed]
- Telkov, M.V.; Demina, G.; Voloshin, S.A.; Salina, E.G.; Dudik, T.V.; Stekhanova, T.N.; Mukamolova, G.V.; Kazaryan, K.A.; Goncharenko, A.V.; Young, M.; et al. Proteins of the Rpf (resuscitation promoting factor) family are peptidoglycan hydrolases. Biochemistry 2006, 71, 414–422. [Google Scholar] [CrossRef] [PubMed]
- Keep, N.H.W.J.; Robertson, G.; Cohen-Gonsaud, M.; Henderson, B. Bacterial resuscitation factors: Revival of viable but non-culturable bacteria. Cell. Mol. Life Sci. 2006, 63, 2555–2559. [Google Scholar] [CrossRef] [PubMed]
- Al-Tai, A.M.; Ruan, J.S. Nocardiopsis halophila sp. nov., a New Halophilic Actinomycete. Isolated from Soil. Int. J. Syst. Evol. Microbiol. 1994, 44, 474–478. [Google Scholar] [CrossRef]
- Yuan, S.; Chan, H.; Filipek, S.; Vogel, H. Pymol and inkscape bridge the data and the data visualization. Structure 2016, 24, 2041–2042. [Google Scholar] [CrossRef]
- Kumar, S.; Stecher, G.; Li, M.; Knyaz, C.; Tamura, K. MEGA X: Molecular Evolutionary Genetics. Analysis across Computing Platforms. Mol. Biol. Evol. 2018, 35, 1547–1549. [Google Scholar] [CrossRef]
- Macneil, D.J.; Gewain, K.; Ruby, C.L.; Dezeny, G.; Gibbons, P.H.; Macneil, T. Analysis of. Streptomyces avermitilis genes required for avermectin biosynthesis utilizing a novel integration vector. Gene 1992, 111, 61–68. [Google Scholar] [CrossRef]
- Paget, M.S.; Chamberlin, L.; Atrih, A.; Foster, S.J.; Buttner, M.J. Evidence that the extracytoplasmic function sigma factor SigE is required for normal cell wall structure in Streptomyces coelicolor A3(2). J. Bacteriol. 1999, 181, 204–211. [Google Scholar] [CrossRef]
- Cheng, X.Y.; Wang, X.R.; Kang, Q.J.; Li, W.J.; Bai, L.Q. Establishment and Application of. Conjugation System for the Ansamitocin Producer Nocardiopsis ansamitocini EGI80425. Jiyinzuxue Yu Yingyong Shengwuxue (Genom. Appl. Biol.) 2020, 39, 1163–1171. [Google Scholar] [CrossRef]
- Ledoux, M.; Lamy, F. Determination of proteins and sulfobetaine with the Folin-phenol reagent. Anal. Biochem. 1986, 157, 28–31. [Google Scholar] [CrossRef]
- Yewalkar, S.; Wu, T.; Kuan, D.; Wang, H.; Li, D.; Johnson, A. Applicability of differential fluorescein. diacetate and propidium iodide fluorescence staining for monitoring algal growth and viability. Waste Dispos. Sustain. Energy 2019, 1, 199–206. [Google Scholar] [CrossRef]
- Ruggiero, A.; Squeglia, F.; Romano, M.; Vitagliano, L.; Simone, A.D.; Berisio, R. The structure of. Resuscitation p romoting factor B from M. tuberculosis reveals unexpected ubiquitin-like domains. Biochim. Biophys. Acta 2016, 860, 445–451. [Google Scholar] [CrossRef]
- Gong, X.; Lu, H.; Wu, J.; Zhou, Y.; Yang, L.; Wang, Y.; Shen, N.; Jiang, M. Enzymatic properties and biological activity of resuscitation-promoting factor B of Rhodococcus sp. (GX12401). Front. Microbiol. 2022, 13, 965843. [Google Scholar] [CrossRef]
- Lahtinen, S.J.; Ahokoski, H.; Reinikainen, J.P. Degradation of 16S rRNA and attributes of viability of viable but nonculturable probiotic bacteria. Lett. Appl. Microbiol. 2008, 46, 693–698. [Google Scholar] [CrossRef]
- Machado, A.; Bordalo, A.A. Diversity and dynamics of the Vibrio community in well water used for drinking in Guinea-Bissau (West Africa). Environ. Monit. Assess. 2014, 186, 5697–5709. [Google Scholar] [CrossRef]
- Liu, G.; Han, Y.; Xi, L.; Song, S. Applicability of a rapid method based on immunomagnetic capture-fluorescent PCR assay for Campylobacter jejuni. Food Control 2006, 17, 527–532. [Google Scholar] [CrossRef]
- Khan, M.M.T.; Pyle, B.H.; Camper, A.K. Specific and Rapid Enumeration of Viable but Nonculturable and Viable-Culturable Gram-Negative Bacteria by Using Flow Cytometry. Appl. Environ. Microbiol. 2010, 76, 5088–5096. [Google Scholar] [CrossRef]
- Berney, M.; Hammes, F.; Bosshard, F.; Weilenmann, H.U.; Egli, T. Assessment and interpretation of bacterial viability by using the LIVE/DEAD BacLight Kit in combination with flow cytometry. Appl. Environ. Microbiol. 2007, 73, 3283–3290. [Google Scholar] [CrossRef]
- Wang, Y.; Claeys, L.; Ha, D.; Verstraete, W.; Boon, N. Effects of chemically and electrochemically dosed chlorine on Escherichia coli and Legionella beliardensis assessed by flow cytometry. Appl. Microbiol. Biotechnol. 2010, 87, 331–341. [Google Scholar] [CrossRef]
- Pereira, S.F.; Goss, L.; Dworkin, J. Eukaryote-like serine/threonine kinases and phosphatases in bacteria. Microbiol. Mol. Biol. Rev. 2011, 75, 192–212. [Google Scholar] [CrossRef]
- Virmani, R.; Sajid, A.; Singhal, A.; Gaur, M.; Joshi, J.; Bothra, A.; Garg, R.; Misra, R.; Singh, V.P.; Molle, V.; et al. The Ser/Thr protein kinase PrkC imprints phenotypic memory in Bacillus anthracis spores by phosphorylating the glycolytic enzyme enolase. J. Biol. Chem. 2019, 294, 8930–8941. [Google Scholar] [CrossRef] [PubMed]

| Strain or Plasmid | Description | Source or Reference |
|---|---|---|
| Strains | ||
| E. coli DH5α | Strain used for cloning and plasmid maintenance | Sangon Biotech |
| E. coli BL21 codon plus (DE3) | Strain used for protein expression | Sangon Biotech |
| E.coli ET12567(pUZ8002) | Dam dcm, with transmobilizing plasmid pUZ8002 | [47,48] |
| N.halophila CGMCC 4.1195T | Strain used for amplification of rpf gene. | [43] |
| Plasmids | ||
| pMD18-T | Ampr cloning vector | TaKaRa |
| pMD18-T:rpf | pMD18-T containing rpf from strain CGMCC 4.1195T | This study |
| pET 28a(+) | Ampr expression vector | TaKaRa |
| pET 28a(+):rpf | pET 28a(+) containing rpf from strain CGMCC 4.1195T | This study |
| pJTU1278 | Conjugation vectors used for rpf gene knockout | [49] |
| pJTU1278: left arm | pJTU1278 carrying the homologous arm of rpf | This study |
| pJTU1278: left/Right | pJTU1278 carrying the left and right homologous arms of rpf | This study |
| Fragment | Primers | Sequence (5′-3′) | Restriction Enzyme |
|---|---|---|---|
| rpf | rpf-F | GGAATTCGGAAGAACCGTGCGCAAT | EcoRI |
| rpf-R | CCGCTCGAGCATATGCTCAGTCGAACAGGTGGC | XholI | |
| Left homologous arm of rpf | L-F | GCTCTAGAGGGCCTCAGGGGAGCTCCACGC | XbaI |
| L-R | CGGGATCCGCCGCCGCGGCTCCGGTG | BamHI | |
| Right homologous arm of rpf | R-F | CGGGATCCGCCAGTGGCCCGAATGCG | BamHI |
| R-R | CCCAAGCTTGCCAGGAGACGGTGGCCC | HindIII |
Disclaimer/Publisher’s Note: The statements, opinions and data contained in all publications are solely those of the individual author(s) and contributor(s) and not of MDPI and/or the editor(s). MDPI and/or the editor(s) disclaim responsibility for any injury to people or property resulting from any ideas, methods, instructions or products referred to in the content. |
© 2023 by the authors. Licensee MDPI, Basel, Switzerland. This article is an open access article distributed under the terms and conditions of the Creative Commons Attribution (CC BY) license (https://creativecommons.org/licenses/by/4.0/).
Share and Cite
Zhang, Y.; Liu, J.; Cao, M.; Zhang, Y.; Zhang, X. Role of Resuscitation Promoting Factor-like Protein from Nocardiopsis halophila. Microorganisms 2023, 11, 485. https://doi.org/10.3390/microorganisms11020485
Zhang Y, Liu J, Cao M, Zhang Y, Zhang X. Role of Resuscitation Promoting Factor-like Protein from Nocardiopsis halophila. Microorganisms. 2023; 11(2):485. https://doi.org/10.3390/microorganisms11020485
Chicago/Turabian StyleZhang, Yufan, Jingjing Liu, Min Cao, Yujia Zhang, and Xiumin Zhang. 2023. "Role of Resuscitation Promoting Factor-like Protein from Nocardiopsis halophila" Microorganisms 11, no. 2: 485. https://doi.org/10.3390/microorganisms11020485
APA StyleZhang, Y., Liu, J., Cao, M., Zhang, Y., & Zhang, X. (2023). Role of Resuscitation Promoting Factor-like Protein from Nocardiopsis halophila. Microorganisms, 11(2), 485. https://doi.org/10.3390/microorganisms11020485






